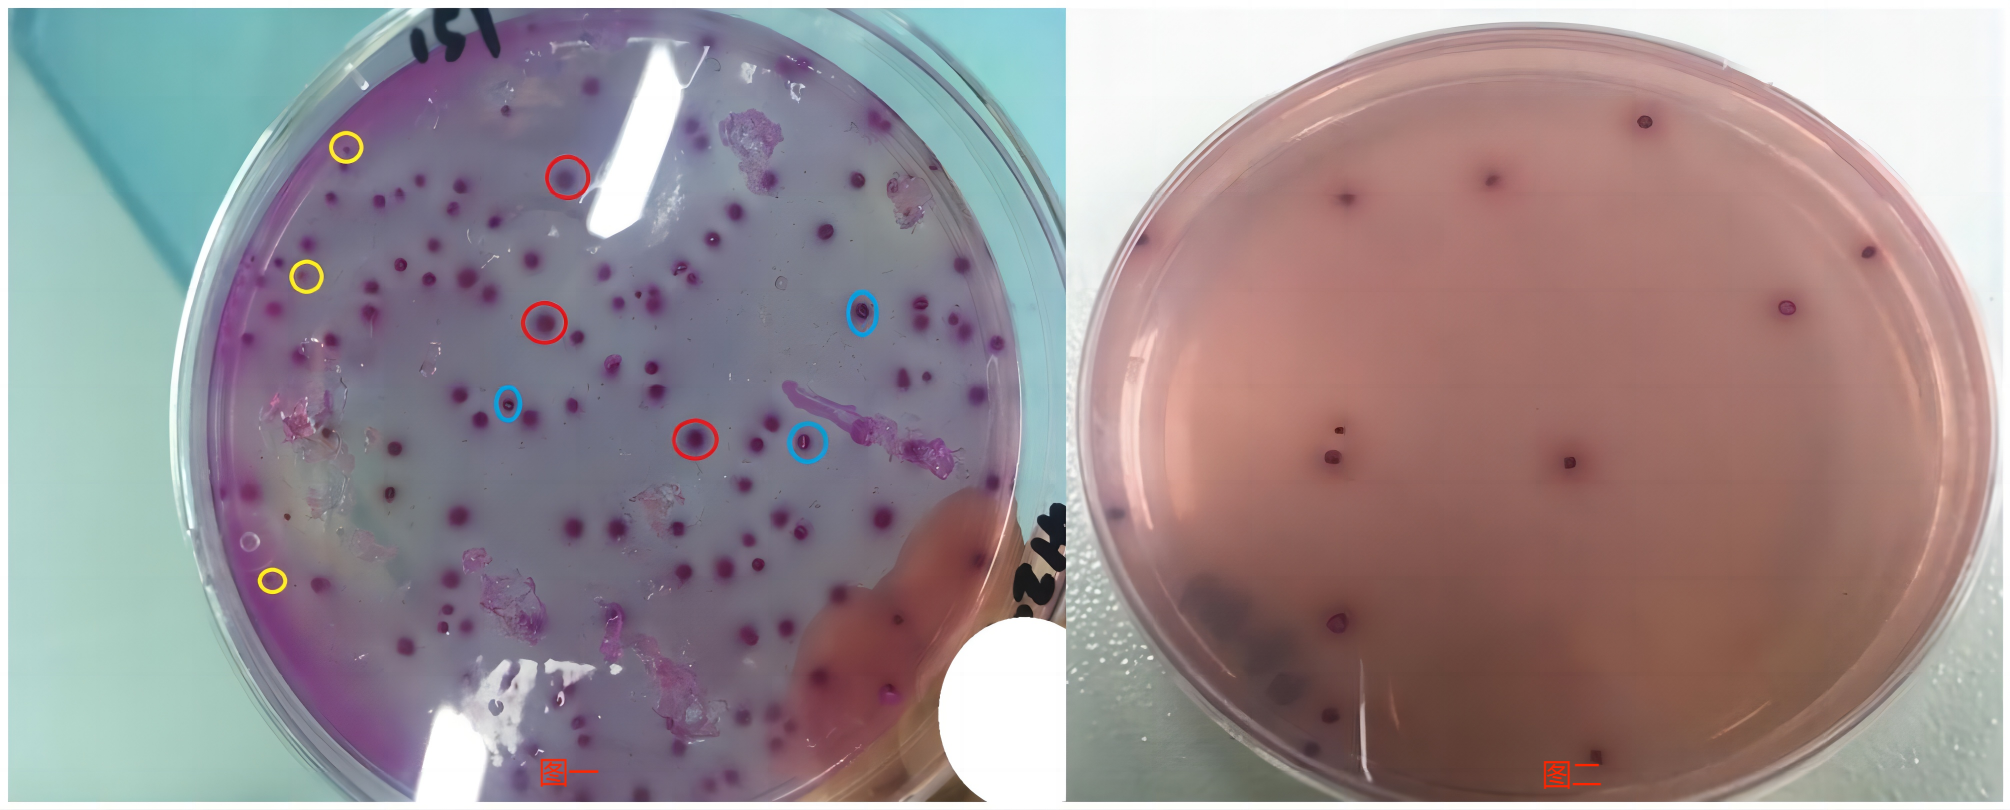
大肠菌群菌落计数

大肠菌群能力验证不会做?听资深检测人员按流程讲解心得体会
发布时间:2025-05-09 浏览次数:3449
来源:“食品微生物检测”公众号 作者:岳正华
原标题:大肠菌群能力验证不会做?听资深检测人员按流程讲解心得体会
前不久,参加了中检院“乳粉中大肠菌群的检测能力验证”心情有点小紧张,此次大肠菌群以定量的方式进行考核,样品为2个,西林瓶真空包装,呈白色冻干块状,每个样等同于60.0mL的待测乳品样品。
大肠能力验证实验
1
收到样品后,确认样品包装是否完好,并将其保存在2~8℃冰箱中,然后在能力验证平台进行确认。
2
方法选择和人员比对的探讨:
根据能力验证参试指导书确定测试方法,样品为待测乳品,乳品判定标准常采用平板法,首选GB4789.3-2016中第二法《大肠菌群平板计数法》。样品稀释梯度到10-4,第一法《大肠菌群MPN计数法》作为方法比对,样品稀释梯度到10-6;与此同时,选择快速纸片法做参考,纸片选取来自美国和日本两个厂家的大肠菌群测试片进行测定。
人员比对为两人,分别选取市面上两家不同厂家(如环凯生物)的培养基进行测试比对。
3
进行实验,将样品从冰箱中取出达到室温后开启使用,在生物安全柜下先用5mL稀释液(选取的生理盐水)进行水化后吸入无菌瓶或袋中,再用剩余的55mL稀释液进行洗涤并转入无菌瓶或袋中。
洗涤转移时注意样品瓶盖的清洗和无菌操作,将60mL的样品进行均质混匀,原液立刻进行接种;再取25mL到225mL稀释液中均质混匀,制成10-1梯度样品匀液,乳液中含有蛋白质具有发泡性,均质时易产生较多气泡,会影响体积,导致结果偏低,为减少误差可从原液中取25mL到225mL稀释液中手动混匀,混匀时注意观察产生气泡的多少。
用1mL无菌吸管取1:10的样液到9mL生理盐水试管中,制成1:100的样液,以此类推。再将几个稀释度的样液接种到无菌平皿和LST肉汤中。从样品的制备到接种全程应不超过15分钟,然后在36℃中培养,平板和纸片24h,LST肉汤发酵管24~48h。
4
在培养18h时观察发酵管产气情况,纸片和平板的菌落生长情况并进行初步计数,待时间到时进行具体的菌落计数,在菌落数为15-150之间的平板上选取可疑的紫红色较小菌落5个如图(一)中黄圈标注;选取紫红色周围有红色胆盐沉淀环的较大典型菌落5个,如图(一)中红圈标注;选取可疑紫红色似有破痕的菌落5个,如图(一)中蓝圈标注,进行验证。对LST肉汤发酵管中产气管进行复发酵证实实验。为求准确挑取图一的下一个梯度平板上的所有菌落作确认,如图(二)。
5
观察可疑菌落在BGLB中产气情况,如下图(三),图中菌落形态小的产气量最大,菌落形态大的反而产气量最小,说明产气量多少不以其形态的大小来衡量,而是以菌含量的高低判断。

6
结果的计算和对比:

对上述结果分析可知采用两个不同厂家的培养基进行平板法和MPN法测试,检验结果未见显著差异。采用纸片法,不论是国外厂家还是国内广东环凯厂家的大肠菌群测试片在低浓度时,检测结果与国标法差异不大,但是随着样品浓度的增加,检测结果相对国标法有较大的差异。其中纸片作为一种快速测试方法,其优越性也显而易见,操作简单,判读明确,缩短检测时间,可作为一种快速筛选的方法。
7
在对结果进行分析后,选取平板法的检测结果的平均值进行网络提交。
最后,收到中期报告,两个样的Z值分别为+0.1和-0.3,在偏差±2.0范围内结果满意。
望此次试验经历和心得能够给与做微生物的小伙伴们一点小小借鉴,同时也希望同行给与更多的建议。
说明:转载仅为分享目的,部分文章图片因转载众多无法确认原始作者的,仅标明转载来源;版权归原作者所有,如有问题,请联系小编删除,谢谢!






